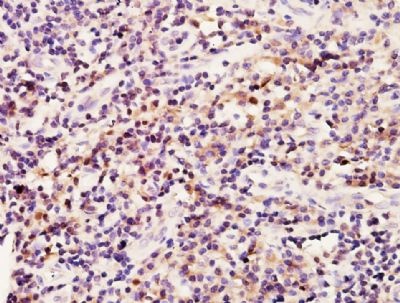
产品细节图片2

相关产品推荐更多 >
万千商家帮你免费找货
0 人在求购买到急需产品
- 详细信息
- 文献和实验
- 技术资料
- 供应商:
上海康朗生物科技有限公司
- 库存:
大量
- 目录编号:
kl-0802R
- 克隆性:
多克隆
- 抗原来源:
Rabbit
- 保质期:
12个月
- 抗体英文名:
BRCA1 antibody
- 抗体名:
乳腺癌易感基因1抗体
- 宿主:
Rabbit
- 适应物种:
Human
- 免疫原:
KLH conjugated synthetic peptide derived from human BRCA1:931-1030/1863
- 亚型:
IgG
- 形态:
冻干粉或液体
- 应用范围:
ELISA=1:500-1000 IHC-P=1:400-800 IHC-F=1:400-800 IF=1:100-500
- 浓度:
1mg/ml
- 保存条件:
-20 °C
- 规格:
50ul 100ul 200ul
| 中文名称 | 乳腺癌易感基因1抗体 |
| 别 名 | BRCA 1; BRCA1; BRCA1/BRCA2 containing complex subunit 1; BRCA1/BRCA2-containing complex, subunit 1; BRCA1_HUMAN; BRCAI; BRAC 1; BRCA 1; BRCC 1; BRCC1; Breast Cancer 1; Breast Cancer 1 Early Onset; Breast cancer type 1 susceptibility protein; Breast and ovarian cancer susceptibility protein 1; Breast Ovarian Cancer Susceptibility; IRIS; Papillary Serous Carcinoma Of The Peritoneum; PSCP; RING finger protein 53; BROVCA1; IRIS; PNCA4; PPP1R53; Protein phosphatase 1 regulatory subunit 53; RNF53; BAP1. |
| 规格价格 | 50ul/780元 购买 100ul/1380元 购买 200ul/2200元 购买 大包装/询价 |
| 说 明 书 | 50ul 100ul 200ul |
| 研究领域 | 肿瘤 细胞生物 免疫学 染色质和核信号 表观遗传学 |
| 抗体来源 | Rabbit |
| 克隆类型 | Polyclonal |
| 交叉反应 | Human, |
| 产品应用 | ELISA=1:500-1000 IHC-P=1:400-800 IHC-F=1:400-800 IF=1:100-500 (石蜡切片需做抗原修复) not yet tested in other applications. optimal dilutions/concentrations should be determined by the end user. |
| 分 子 量 | 208kDa |
| 细胞定位 | 细胞核 细胞浆 |
| 性 状 | Lyophilized or Liquid |
| 浓 度 | 1mg/ml |
| 免 疫 原 | KLH conjugated synthetic peptide derived from human BRCA1:931-1030/1863 |
| 亚 型 | IgG |
| 纯化方法 | affinity purified by Protein A |
| 储 存 液 | 0.01M TBS(pH7.4) with 1% BSA, 0.03% Proclin300 and 50% Glycerol. |
| 保存条件 | Store at -20 °C for one year. Avoid repeated freeze/thaw cycles. The lyophilized antibody is stable at room temperature for at least one month and for greater than a year when kept at -20°C. When reconstituted in sterile pH 7.4 0.01M PBS or diluent of antibody the antibody is stable for at least two weeks at 2-4 °C. |
| PubMed | PubMed |
| 产品介绍 | background: This gene encodes a nuclear phosphoprotein that plays a role in maintaining genomic stability, and it also acts as a tumor suppressor. The encoded protein combines with other tumor suppressors, DNA damage sensors, and signal transducers to form a large multi-subunit protein complex known as the BRCA1-associated genome surveillance complex (BASC). This gene product associates with RNA polymerase II, and through the C-terminal domain, also interacts with histone deacetylase complexes. This protein thus plays a role in transcription, DNA repair of double-stranded breaks, and recombination. Mutations in this gene are responsible for approximately 40% of inherited breast cancers and more than 80% of inherited breast and ovarian cancers. Alternative splicing plays a role in modulating the subcellular localization and physiological function of this gene. Many alternatively spliced transcript variants, some of which are disease-associated mutations, have been described for this gene, but the full-length natures of only some of these variants has been described. A related pseudogene, which is also located on chromosome 17, has been identified. [provided by RefSeq, May 2009]. Function: E3 ubiquitin-protein ligase that specifically mediates the formation of 'Lys-6'-linked polyubiquitin chains and plays a central role in DNA repair by facilitating cellular responses to DNA damage. It is unclear whether it also mediates the formation of other types of polyubiquitin chains. The E3 ubiquitin-protein ligase activity is required for its tumor suppressor function. The BRCA1-BARD1 heterodimer coordinates a diverse range of cellular pathways such as DNA damage repair, ubiquitination and transcriptional regulation to maintain genomic stability. Regulates centrosomal microtubule nucleation. Required for normal cell cycle progression from G2 to mitosis. Required for appropriate cell cycle arrests after ionizing irradiation in both the S-phase and the G2 phase of the cell cycle. Involved in transcriptional regulation of P21 in response to DNA damage. Required for FANCD2 targeting to sites of DNA damage. May function as a transcriptional regulator. Inhibits lipid synthesis by binding to inactive phosphorylated ACACA and preventing its dephosphorylation. Contributes to homologous recombination repair (HRR) via its direct interaction with PALB2, fine-tunes recombinational repair partly through its modulatory role in the PALB2-dependent loading of BRCA2-RAD51 repair machinery at DNA breaks. Subunit: Heterodimer with BARD1. Part of the BRCA1-associated genome surveillance complex (BASC), which contains BRCA1, MSH2, MSH6, MLH1, ATM, BLM, PMS2 and the RAD50-MRE11-NBN protein complex. This association could be a dynamic process changing throughout the cell cycle and within subnuclear domains. Component of the BRCA1-A complex, at least composed of the BRCA1, BARD1, UIMC1/RAP80, FAM175A/Abraxas, BRCC3/BRCC36, BRE/BRCC45 and BABAM1/NBA1. Interacts (via BRCT domains) with FAM175A/Abraxas and RBBP8. Associates with RNA polymerase II holoenzyme. Interacts with SMC1A and COBRA1/NELFB. Interacts (via BRCT domains) with phosphorylated BRIP1. Interacts with FANCD2 (ubiquitinated). Interacts with BAP1. Interacts with DCLRE1C/Artemis and CLSPN. Interacts with H2AFX (phosphorylated on 'Ser-140'). Interacts with CHEK1 and CHEK2. Interacts with BRCC3. Interacts (via BRCT domains) with ACACA (phosphorylated); the interaction prevents dephosphorylation of ACACA. Interacts with AURKA. Interacts with UBXN1. Part of a trimeric complex containing BRCA1, BRCA2 and PALB2. Interacts with PALB2 and this interaction is essential for its function in HRR. Interacts with BRCA2 only in the presence of PALB2 which serves as the bridging protein. Subcellular Location: Cytoplasm; Nucleus. Localizes at sites of DNA damage at double-strand breaks (DSBs) and recruitment to DNA damage sites is mediated by the BRCA1-A complex. Tissue Specificity: Isoform 1 and isoform 3 are widely expressed. Isoform 3 is reduced or absent in several breast and ovarian cancer cell lines. Post-translational modifications: Phosphorylation at Ser-308 by AURKA is required for normal cell cycle progression from G2 to mitosis. Phosphorylated in response to IR, UV, and various stimuli that cause checkpoint activation, probably by ATM or ATR. Phosphorylation at Ser-988 by CHEK2 regulates mitotic spindle assembly. Autoubiquitinated, undergoes 'Lys-6'-linked polyubiquitination. 'Lys-6'-linked polyubiquitination does not promote degradation. DISEASE: Defects in BRCA1 are a cause of susceptibility to breast cancer (BC) [MIM:114480]. A common malignancy originating from breast epithelial tissue. Breast neoplasms can be distinguished by their histologic pattern. Invasive ductal carcinoma is by far the most common type. Breast cancer is etiologically and genetically heterogeneous. Important genetic factors have been indicated by familial occurrence and bilateral involvement. Mutations at more than one locus can be involved in different families or even in the same case. Note=Mutations in BRCA1 are thought to be responsible for 45% of inherited breast cancer. Moreover, BRCA1 carriers have a 4-fold increased risk of colon cancer, whereas male carriers face a 3-fold increased risk of prostate cancer. Cells lacking BRCA1 show defects in DNA repair by homologous recombination. Similarity: Contains 2 BRCT domains. Contains 1 RING-type zinc finger. SWISS: P38398 Gene ID: 672 Database links: Entrez Gene: 672 Human Omim: 113705 Human SwissProt: P38398 Human Unigene: 194143 Human Important Note: This product as supplied is intended for research use only, not for use in human, therapeutic or diagnostic applications. BRCA1基因是最早被发现的乳腺癌易感基因其突变和家族性乳腺癌、卵巢癌的发病有关 |
| 产品图片 | ![]() Paraformaldehyde-fixed, paraffin embedded (Human neurilemmoma); Antigen retrieval by boiling in sodium citrate buffer (pH6.0) for 15min; Block endogenous peroxidase by 3% hydrogen peroxide for 20 minutes; Blocking buffer (normal goat serum) at 37°C for 30min; Antibody incubation with (BRCA1) Polyclonal Antibody, Unconjugated (bs-0802R) at 1:400 overnight at 4°C, followed by operating according to SP Kit(Rabbit) (sp-0023) instructionsand DAB staining. ![]() Tissue/cell: Human nasopharyngeal carcinoma; 4% Paraformaldehyde-fixed and paraffin-embedded; Antigen retrieval: citrate buffer ( 0.01M, pH 6.0 ), Boiling bathing for 15min; Block endogenous peroxidase by 3% Hydrogen peroxide for 30min; Blocking buffer (normal goat serum,C-0005) at 37℃ for 20 min; Incubation: Anti-BRCA1/BAP1 Polyclonal Antibody, Unconjugated(bs-0802R) 1:200, overnight at 4°C, followed by conjugation to the secondary antibody(SP-0023) and DAB(C-0010) staining |
风险提示:丁香通仅作为第三方平台,为商家信息发布提供平台空间。用户咨询产品时请注意保护个人信息及财产安全,合理判断,谨慎选购商品,商家和用户对交易行为负责。对于医疗器械类产品,请先查证核实企业经营资质和医疗器械产品注册证情况。
文献和实验Development of a Scoring System to Screen for BRCA1/2 Mutations
Selection for genetic testing for pathogenic mutations in BRCA1 and BRCA2 is an important area of healthcare. While testing costs for mutational analysis are falling, costs of tests in North America remain in excess of $3,000. Most countries
Developing Functional Assays for BRCA1 Unclassified Variants
Women with a family history of breast cancer have mutations in one of the breast cancer susceptibility genes, BRCA1 or BRCA2 . Since the discovery of these two genes, around 100,000 women worldwide have undergone genetic testing
Ovarian Cancer Gene Therapy with BRCA1An Overview
The human breast and ovarian cancer susceptibility gene BRCA1 is a tumorsuppressor gene which is mutated and lost in hereditary breast and ovarian cancer, and has both alleles mutated in approximately 10-15% of cases of sporadic ovarian cancer
技术资料暂无技术资料 索取技术资料